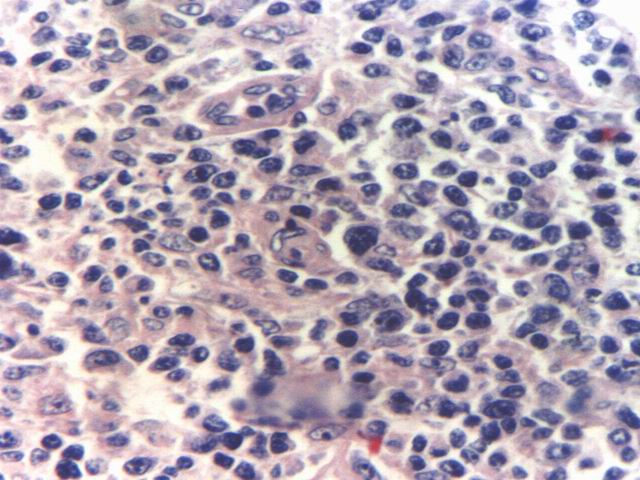
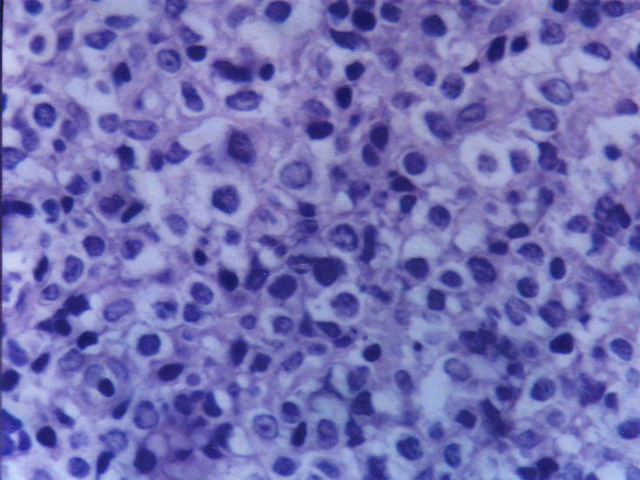

|
ESPECTRO DE LINFOMAS DE ESTIRPE CELULAR B EN JUJUY, NOROESTE DE ARGENTINA. Oscar Marin* |
|
|
INTRODUCCION:
En nuestro hospital se registran 531 casos de afecciones linfoproliferativas entre 1978 y enero 2005. Entre ellas se registran 287 (54 %)casos de linfomas no Hodgkin de estirpe celular B. 81 c de Enfermedad de Hodgkin (15.3 %), 127 casos de Linfomas de células T/NK (24 %) Y 36 casos No Clasificados (6.8 %). El propósito de este trabajo es conocer la incidencia relativa de los subtipos de linfomas de células B en nuestro medio. Nuestra provincia presenta diferentes áreas geográficas: selváticas, montañosas, deserticas etc, con diferentes patologías observadas según regiones. Además habitada por elevado porcentaje de descendientes de amerindios, en los cuales las patologías registradas tienen diferente incidencia que entre descendientes de europeos.
MATERIAL Y METODOS:
Se estudiaron 287 casos de linfomas de estirpe celular B registrados en el Servicio de Anatomía Patológica del Hospital "Pablo Soria" de Jujuy. Este hospital recibe la casi totalidad de biopsias de la provincia en el área estatal a excepción de un solo hospital. Las muestras se estudiaron mediante Hematoxilina-Eosina, Gomori, Giemsa y P.A.S en forma rutinaria. Estudios de Inmunohistoquímica realizados con CD20 y / o CD79a, CD3, Cadenas livinas de Inmunoglobulinas Kappa y Lambda, Bcl-2, Ciclina D1, CD30, CD8, CD5 y en algunos casos LN1, LN2, LN3.
RESULTADOS:
Se registran 12c (4.1 %) de Leucemia Linfocitica Crónica B (B-CLL), 7 casos (2.4 %) de Linfoma de Burkitt (uno asociado a HIV), 152 c (52.7 % ) corresponden a Linfoma Difuso de Grandes Células B (DLBCL), 22 casos (7.6 %) de Linfoma Folicular (FL), 15c (5.2 %) casos de IPSID (Immunoproliferative Small Intestinal Disease), 14c (4.8 %) Linfoma Linfoblastico B, 12 c (4.1 %)corresponden a linfomas de tipo Linfoplasmocítico, en 9 c (3.1 %) se estableció el diagnóstico de linfoma del Manto (MCL), 14 c (4.8 %) corresponden a Mieloma Multiple y 27 casos (9.4 %) a Linfomas de la zona Marginal (MZL). Dentro de los DLBCL se encuentran 139 casos (48.6 %) )de las variedades centroblastica e inmunoblastica, 7 casos (2.4 %) de DLBCL asociados a HIV, 2 casos (2.4 %) de Linfoma Mediastinal B, 1 c (0.3 %) de Linfoma B rico en células T (TCRBCL) y 2 c (2.4 %) de Linfoma Plasmoblastico asociado a HIV y 1 caso de PEL (Pleural Effussion Lymphoma) . Entre 27 c (9.4 %) linfomas de la Zona Marginal (MZL) se encuentran 8 c (2.7 %) de ubicación gástrica, 3 c (1 %) intestinales, 3 c (1 %) en parótida, 5 c (1.7 %) en piel, 1c (1.7 %) en pulmón y 2c (2.4 %) ganglionares (MZL-Nodal). En 3 c (1 %) se estableció el diagnóstico de MZL-MALT en Tiroides, todos ellos acompañados de componente DLBCL. 3 casos de linfomas gástricos presentaban componente MZL-MALT y DLBCL simultáneamente.
DISCUSION:
En nuestra serie se registra una elevada incidencia de Linfomas Difusos de Grandes Células B, si bien estos se han reportado asociados a desnutrición (algo no desconocido en nuestra provincia) también es el linfoma mas frecuente tanto en series Asiáticas como Occidentales. Las variantes Clínico-patológicas de estos no presentan elevada incidencia en nuestra serie. El linfoma folicular habitualmente reportado como uno de los más frecuentes en nuestro estudio solo representa el 7 % de los linfomas de células B. Mientras que linfomas de tipo MZL registran una incidencia de 9 %. Los casos de linfomas linfoblasticos prácticamente todos provenientes del hospital de niños de Jujuy. El grupo mieloma-Plasmocitoma tampoco registra elevada incidencia entre nuestros casos. A diferencia de series occidentales registramos una baja incidencia de linfomas de tipo Folicular y de Mieloma-Plasmocitoma. El elevado número de linfomas de tipo DLBCL, la baja incidencia de FL y una moderadamente elevada tasa de MZL muestran mayor similitud con series orientales que occidentales. Posiblemente un factor racial se encuentra involucrado. Un componente diferente de nuestra serie es la presencia de IPSID linfoma raro en series occidentales y orientales, pero de elevada incidencia en países del III mundo. Nuestra provincia luego de años de devastación económica que afecta a grandes sectores de la población, parece tener sentadas las bases para la aparición de este linfoma.
|
||
|
|
En nuestro hospital se registran 531 casos de afecciones linfoproliferativas entre 1978 y enero 2005. Entre ellas se registran 287 (54 %)casos de linfomas no Hodgkin de estirpe celular B. 81 c de Enfermedad de Hodgkin (15.3 %), 127 casos de Linfomas de células T/NK (24 %) y 36 casos NC-No Clasificados (6.8 %). Nuestra provincia presenta diferentes áreas geográficas: selváticas, montañosas, deserticas etc, con diferentes patologías observadas según regiones. Además habitada por elevado porcentaje de descendientes de amerindios, en los cuales las patologías registradas tienen diferente incidencia que entre descendientes de europeos. Sin embargo y pese a ser los linfomas más habituales, no se han realizado estudios acerca de linfomas con estirpe celular B en nuestra serie, opacados por la presencia de linfomas de tipo ATLL (Adult T-cell Lymphoma/leukemia) y T/NK de tipo nasal, que consitaron nuestra atención y esfuerzo en estos años.
El propósito de este trabajo es conocer la incidencia relativa de los subtipos de linfomas de células B en nuestro medio.
|
|
|
|
Se estudiaron 287 casos de linfomas de estirpe celular B registrados en el Servicio de Anatomía Patológica del Hospital "Pablo Soria" de Jujuy. Este hospital recibe la casi totalidad de biopsias de la provincia en el área estatal a excepción de un solo hospital. Las muestras se estudiaron mediante Hematoxilina-Eosina, Gomori, Giemsa y P.A.S en forma rutinaria. Estudios de Inmunohistoquímica realizados con CD20 y / o CD79a, CD3, Cadenas livinas de Inmunoglobulinas Kappa y Lambda, Bcl-2, Ciclina D1, CD30, CD8, CD5 y en algunos casos LN1, LN2, LN3.
|
|
|
|
Se registran:
12c (4.1 %) de Leucemia Linfocitica Crónica B (B-CLL).
7 casos (2.4 %) de Linfoma de Burkitt (uno asociado a HIV).
152 c (52.7 % ) corresponden a Linfoma Difuso de Grandes Células B (DLBCL).
22 casos (7.6 %) de Linfoma Folicular (FL).
15c (5.2 %) casos de IPSID (Immunoproliferative Small Intestinal Disease).
14c (4.8 %) Linfoma Linfoblastico B.
12 c (4.1 %)corresponden a linfomas de tipo Linfoplasmocítico.
9 c (3.1 %) se estableció el diagnóstico de linfoma el Manto (MCL).
14 c (4.8 %) corresponden a Mieloma Multiple.
27 casos (9.4 %) a Linfomas de la zona Marginal (MZL).
Dentro de los DLBCL se encuentran 139 casos (48.6 %) )de las variedades centroblastica e inmunoblastica, 7 casos (2.4 %) de DLBCL asociados a HIV, 2 casos (2.4 %) de Linfoma Mediastinal B, 1 c (0.3 %) de Linfoma B rico en células T (TCRBCL) y 2 c (2.4 %) de Linfoma Plasmoblastico asociado a HIV y 1 caso de PEL (Pleural Effussion Lymphoma) .
Entre 27 c (9.4 %) linfomas de la Zona Marginal (MZL) se encuentran 8 c (2.7 %) de ubicación gástrica, 3 c (1 %) intestinales, 3 c (1 %) en parótida, 5 c (1.7 %) en piel, 1c (1.7 %) en pulmón y 2c (2.4 %) ganglionares (MZL-Nodal). En 3 c (1 %) se estableció el diagnóstico de MZL-MALT en Tiroides, todos ellos acompañados de componente DLBCL.
3 casos de linfomas gástricos presentaban componente MZL-MALT y DLBCL simultáneamente.
|
|
|
|
En nuestra serie se registra una elevada incidencia de Linfomas Difusos de Grandes Células B. Si bien estos se han reportado asociados a desnutrición (algo no desconocido en nuestra provincia) también es el linfoma mas frecuente tanto en series Asiáticas como Occidentales. Entre las variantes morfológicas es destacado el número de linfomas de tipo centroblastico, en superior proporción a los de tipo inmunoblastico, ALCL o TCRBCL. Las variantes Clínico-patológicas de estos(Linfoma Plasmoblastico de la cavidad oral, Linfoma Mediastinal B etc) no presentan elevada incidencia en nuestra serie. Como grupo en general se ha mostrado como un linfoma agresivo, con pobre índice de sobrevida, lo tardío de los diagnósticos, en razón de tener nuestra provincia zonas geográficas aisladas, con zonas montañosas, selváticas, desérticas, con difícil acceso puede contribuir a esta mala evuloción. También la presencia de alta incidencia de tuberculosis en nuestra provincia, actúa a modo de encubridor de linfomas. Una práctica muy arraigada en la provincia es la de tratar casos con adenopatía y fiebre como una tuberculosis y ante la falta de respuesta recién realizar la biopsia ganglionar, lo que colabora tal vez con la mala sobrevida. 5 casos de linfomas de tipo DLBCL tenían ubicación topográfica intestinal en pacientes HIV+. El linfoma folicular habitualmente reportado como uno de los más frecuentes en nuestro estudio solo representa el 7 % de los linfomas de células B. En este aspecto desconocemos si la elevada frecuencia de casos extraganglionares contribuye a una disminución "relativa" de la incidencia de linfomas foliculares mayormente ganglionares o si el diagnóstico en general tardío en nuestro medio, puede llevar a la desaparición del patrón folicular en algunos casos, tornandose en linfomas difusos. El linfoma Folicular también es de baja frecuencia en países asiáticos y basados en la similitud racial de las etnias amerindias, que habitan en nuestro medio y donde se registran patologías de tipo Asiáticas como ATLL, Linfomas NK/T de tipo nasal o de Paraparesia Espástica Tropical relacionada a HTLV-1, puede ser debido a una predisposición racial. De los casos de linfomas Folicular de nuestra serie 5 corresponden a pacientes que provenían del medio privado (donde la población es mayormente de tipo europeo) lo que apoya una cierta noción de etnicidad en el bajo porcentaje de casos de linfoma Folicular entre nuestros casos.
Entre los casos de Leucemia Linfocítica Crónica (12) se encuentran 8 casos antes diagnosticados como Linfomas Linfoplasmocitoides de la clasificaciónde Kiel, considerados ahora en la clasificación de la OMS como pertenecientes a la leucemia linfocitica crónica. Linfoma de células del Manto fué diagnosticado en 9 oportunidades, 2 de ellos procedián en interconsulta de la provincia de Salta. Linfoma de Burkitt mayormente fue encontrado en pacientes pediátricos, con localización intestinal, mandibular u ovárica, excepto por un caso intestinal en paciente adulto jóven HIV+.
Mientras que linfomas de tipo MZL registran una incidencia de 9 % y se encuentran mas frecuentemente en Estómago, Glándulas Salivales, Tiroides y solo un caso en pulmón. Entre los casos gástricos a los últimos 4 pacientes se les realizó terapia para erradicación de Helicobacter Pylori, con biopsias de control mensual, desapareciendo en linfoma entre 4 y 5 meses luego de la terapia. Uno de estos casos fué rebelde a la terapeútica, con desaparición finalmente del linfoma, pero insólita persistencia de H. pylori. Pese a reforzarse la terapia con drogas antineoplásicas, el linfoma recidivó en orofarínge.
Los casos de linfomas linfoblasticos prácticamente todos provenientes del hospital de niños de Jujuy y coincidentes mayormente con Leucemia Linfoblastica Aguda en sangre periférica.
El grupo mieloma-Plasmocitoma tampoco registra elevada incidencia entre nuestros casos. Los linfomas linfoplasmocíticos no registran gran número, como particularidad muchos casos han sido detectados sin adenopatías y en biopsias de médula ósea.
A diferencia de series occidentales registramos una baja incidencia de linfomas de tipo Folicular y de Mieloma-Plasmocitoma.
El elevado número de linfomas de tipo DLBCL, la baja incidencia de FL y una moderadamente elevada tasa de MZL muestran mayor similitud con series orientales que occidentales. Posiblemente un factor racial se encuentra involucrado. Un componente diferente de nuestra serie es la presencia de IPSID linfoma raro en series occidentales y Asiáticas, reportado primeramente en Oriente medio, pero considerado ahora de elevada incidencia en países del III mundo, reportado en Mexico, India, Pakistán etc. Nuestra provincia luego de años de devastación económica que afecta a grandes sectores de la población, parece tener sentadas las bases para la aparición de este linfoma.
|
|
|
|
Linfomas de estirpe celular B son los más numerosos de nuestra serie, como lo son habitualmente. Registramos una elevada incidencia de Linfomas Difusos de Células B. La variedad morfológica mas frecuente es la de tipo centroblastico abrumadoramente, con solo un caso de TCRBCL y de ALCL.
Una escasa frecuencia de linfomas foliculares y Mieloma/plasmocitomas es observada, mientras que los linfomas de la Zona Marginal de tipo MALT, presentan una relativamente alta frecuencia, los casos ganglionares son muy escasos y no se registran casos esplénicos.
La distribución es mas similar a la de países asiáticos, que occidentales, si bien no es tan marcada como en los casos de estirpe celular T/NK.
|
|
|
|
1) Gatter. K.C, Wranke.R.A. Diffuse Large B-cell Lymphoma en World Health Organization Classification of Tumours. Pathology & Genetics. Tumours of Haematopoietic and Lymphoid Tissue. Jaffe,E.S, Harrys.N.L, Stein,H, Vardinam,J. editores 2001;pp171:174 2) Feller, A.G, Diebold, J. Diffuse Large B-cell Lymphomas. En Histopathology of Nodal and Extranodal non-Hodgkin Lymphomas. Springer, 2004;pp75-99. 3) Anagnostopuolos, I, Dallenbach.F, Stein.H, Diffuse Large B-cell Lymphomas.En Knowles.D Neoplastic Hematopathology. Second Edition: 2001;855-914. 4) Lennert. K, Malignant Lymphoma, Centroblastic. En Malignant Lymphomas others than Hodgkin's Disease. Springer-Verlag. 1978; 346-360. 5) Jaffe ES, Longo DL, Cossman J, Hsu SM, Arnold A, Korsmeyer SJ. Diffuse B-cell lymphoma with T-cell predominance in patient with Follicular lymphoma or pseudo T-cell Lymphoma Lab Invest 1984, 27-28A. 6) Decluze HJ, Anagnostopoulos J, Dallenbach F, Hummel M, Marafioti E, Schneider U, Khun D, Schmitt-Westhausen A, Reichart PA, Gross U, Stein H. Plasmoblastic Lymphomas of the oral cavity: a new entity associated with the Human Immunodeficiency Virus Infection. Blood 1997;89:1413-1420. 7) Delsol G, Lamant L, Mariame B, Pulford K, Dastuge N, Brouset P, Rigal-Huguet F, Al Saati T, Cerreti DP, Morris SW, Mason DY. A new subtype of large B-cell lymphoma expressing the ALK kinase and lacking the 2,5 translocation. Blood 1997; 89:1483-1490. 8) Chan, J.K Unusual and uncommon morphologic variants of Diffuse Large B-cell Lymphomas, en Fletcher.C, Diagnostic Histopathology of Tumors, Churchill-Livingstone, 2000:1162-1164. 9) Tse C.C, Chan J.K, Yuen R.M, Ng C.S. Malignant Lymphoma with myxoid stroma: A new patterns of recognition. Histopathology 1991; 18:31-35. 10) Eyden BP, Cross PA, Harris M, The ultrastructure of signet-ring cells non Hodgkin's lymphoma. 11) Tsang MY, Chan JK, Tang SK, Tse CC, Cheung MM. Large cell lymphoma with fibrillar matrix. Histopathology 1992; 20:80-82. 12) Warnke R, Weiss L, Chan JK, Cleary M, Dorfman R. Tumors of the lymph nodes and spleen. Atlas of tumor pathology AFIP THIR SERIES 1995. 13) Nakamine BP, Masih AS, Strobach RS y col. Immunoblastic lymphoma with abundant clear cytoplasm: A clinicopathologic study of B and T-cell Types. Am J Clin Pathol 1991;96:177-183. 14) Osborne BM, Mackay B, Butler JJ, Ordoñez NG. Large cell lymphoma with microvillus.like projection: a ultrastructural study. Am J Clin Pathol 1983;79:443-450. 15) Hammer RD, Vnencak.Jones CL, Manning SS, Glick AD, Kinney M. Microvillus Lymphoma are B-cell neoplasm that frequently express CD56. Mod Pathol 1998;11:239-246. 16) Van Baarlen J, Schurman HJ, van Unik J. Multilobated non-Hodgkin's Lymphomas: a clinicopathologic entity. Cancer 1988;61:1371-1376. 17) Osborne BM, Butler JJ, Mackay B. Sinusoidal Large Cell (Histyocitic)lymphoma. Cancer 1980; 46:2484-2491. 18) Lai R, Medeiros J, Dabbgad L. Sinusoidal CD30-positive Large B-cell Lymphoma: a morphologic mimic of Anaplastic Large Cell Lymphoma. Mod Pathol 2000; 13:223-228. 19) Erlandon RA, Filippa DA, Unusual non-Hodgkin's Lymphomas and trye Histyocitic Lymphomas. Ultrastruct Pathol 1989;13:249-273. 20) Bernier V, Azar HA. Filiform Large-Cell Lymphomas: an ultrastructural and immunohistqichemical study. Am J Surg Pathol 1987;11:387-396. 21) Font RL, Shields J. Large cell lymphoma of the orbit with microvillous projection (porcupine) lymphomas. Arch Ophtalmol 1985;103:1715-9. 22) Uccini S, Pescarmona E, Ruco L, Barini C, Monarca B, Modesti A. Immunohistochemical characterization of B-cell signet-ring cell lymphoma. Report of a case. Patho, Res Pract 1988;183:497-504. 23) Cross PA, Eyden BP, Harris M. Signet-ring cell lymphoma of T-cell type. J Clin Pathol 1989;42:239-245.
|
|
|
|
- Diana Maite Hernandez Fernandez (12/10/2005 18:56:58)
- Juliana Fariña (16/10/2005 15:01:12)
|
|
|
|
|
Web mantenido y actualizado por el Servicio de informática uclm. Modificado: 16/06/2015 15:10:50
 fiogf49gjkf0dCuadro histológico difuso, células de gran diámetro, con nucleolos evidentes. CD20+, CD3-, CD30-, CD8-">
fiogf49gjkf0dCuadro histológico difuso, células de gran diámetro, con nucleolos evidentes. CD20+, CD3-, CD30-, CD8-">
 fiogf49gjkf0d">
fiogf49gjkf0d">
 fiogf49gjkf0d">
fiogf49gjkf0d">
 fiogf49gjkf0d">
fiogf49gjkf0d">
 fiogf49gjkf0d">
fiogf49gjkf0d">
fiogf49gjkf0d">
fiogf49gjkf0d">
 fiogf49gjkf0dLa neoplasia estaba compuesta por células linfoides de gran diámetro, con nucleolos evicentes, entremezcladas con linfocitos pequeños e histiocitos.">
fiogf49gjkf0dLa neoplasia estaba compuesta por células linfoides de gran diámetro, con nucleolos evicentes, entremezcladas con linfocitos pequeños e histiocitos.">
 fiogf49gjkf0dHistiocitos reactivos mostrando inmunoreactividad para CD68">
fiogf49gjkf0dHistiocitos reactivos mostrando inmunoreactividad para CD68">
 fiogf49gjkf0dLinfocitos reactivos marcados con CD3">
fiogf49gjkf0dLinfocitos reactivos marcados con CD3">
..jpg) fiogf49gjkf0dCD20">
fiogf49gjkf0dCD20">
 fiogf49gjkf0dLinfoma difuso en paciente femenino HIV+. Con tumor en la cavidad bucal que abarca maxilar superior derecho y desplaza cavidad ocular.">
fiogf49gjkf0dLinfoma difuso en paciente femenino HIV+. Con tumor en la cavidad bucal que abarca maxilar superior derecho y desplaza cavidad ocular.">
.jpg) fiogf49gjkf0dCitologia intermedia entre centroblastos, plasmoblastos e inmunoblastos. Estudio inmunohistoquímico: CD20-, CD79a, CD3-, CD8-, Citoqueratina AE1/AE3-, kappa-, Lambda-, CD45(LCA)-, NSE-, Cromogranina-, Vimetina-, Desmina-, Sinaptofisina-, EMA+, CD138+++
">
fiogf49gjkf0dCitologia intermedia entre centroblastos, plasmoblastos e inmunoblastos. Estudio inmunohistoquímico: CD20-, CD79a, CD3-, CD8-, Citoqueratina AE1/AE3-, kappa-, Lambda-, CD45(LCA)-, NSE-, Cromogranina-, Vimetina-, Desmina-, Sinaptofisina-, EMA+, CD138+++
">
 fiogf49gjkf0dCélulas con morfología plasmoblastica.">
fiogf49gjkf0dCélulas con morfología plasmoblastica.">
.jpg) fiogf49gjkf0dCD45(LCA)">
fiogf49gjkf0dCD45(LCA)">
 fiogf49gjkf0dCitoqueratina de amplio espectro AE1/AE3">
fiogf49gjkf0dCitoqueratina de amplio espectro AE1/AE3">
.jpg) fiogf49gjkf0dCD20-, CD3-, EMA+. Ki-67+">
fiogf49gjkf0dCD20-, CD3-, EMA+. Ki-67+">
 fiogf49gjkf0dCD138 (Syndecam)">
fiogf49gjkf0dCD138 (Syndecam)">
 fiogf49gjkf0dAE1/AE3-, CD138+, EMA+, p53+">
fiogf49gjkf0dAE1/AE3-, CD138+, EMA+, p53+">
 fiogf49gjkf0dPaciente femenino, 81 años de edad. HIV-, Derrame pleural. No adenopatías, No masa mediastinal, No hepatoesplenomegalia.">
fiogf49gjkf0dPaciente femenino, 81 años de edad. HIV-, Derrame pleural. No adenopatías, No masa mediastinal, No hepatoesplenomegalia.">
 fiogf49gjkf0d">
fiogf49gjkf0d">
 fiogf49gjkf0d">
fiogf49gjkf0d">
 fiogf49gjkf0dInmunoreactividad para CD20, Kappa+, Lambda-, CD3-">
fiogf49gjkf0dInmunoreactividad para CD20, Kappa+, Lambda-, CD3-">
fiogf49gjkf0dPaciente femenino de 21 años de edad, con Sindrome de Vena cava superior. CD20+. CD3-, CD30-
">
fiogf49gjkf0dPaciente femenino de 21 años de edad, con Sindrome de Vena cava superior. CD20+. CD3-, CD30-
">
 fiogf49gjkf0d">
fiogf49gjkf0d">
 fiogf49gjkf0d">
fiogf49gjkf0d">
 fiogf49gjkf0d">
fiogf49gjkf0d">